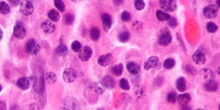
3 minuti faLa giunta regionale dell’Andalusia ha pubblicato per errore i dati clinici di 23 pazienti malati di cancro

Hanoi, Xi Jinping al mausoleo di Ho Chi Minh
-
15/02/2025, 12:58
-
ansa.it
1
Scopri altro
- oggi, 11:10
-
repubblica.it
-
0


- oggi, 05:44
-
quotidiano.net
-
0

- 15/04/2025, 13:58
-
ansa.it
-
1

- 15/04/2025, 13:44
-
ansa.it
-
1

- 15/04/2025, 13:36
-
quotidiano.net
-
1

- 15/04/2025, 13:36
-
ansa.it
-
1

- 15/04/2025, 13:29
-
ilpost.it
-
1

- 15/04/2025, 13:27
-
ansa.it
-
1

- 15/04/2025, 13:25
-
ansa.it
-
1

Nessun commento